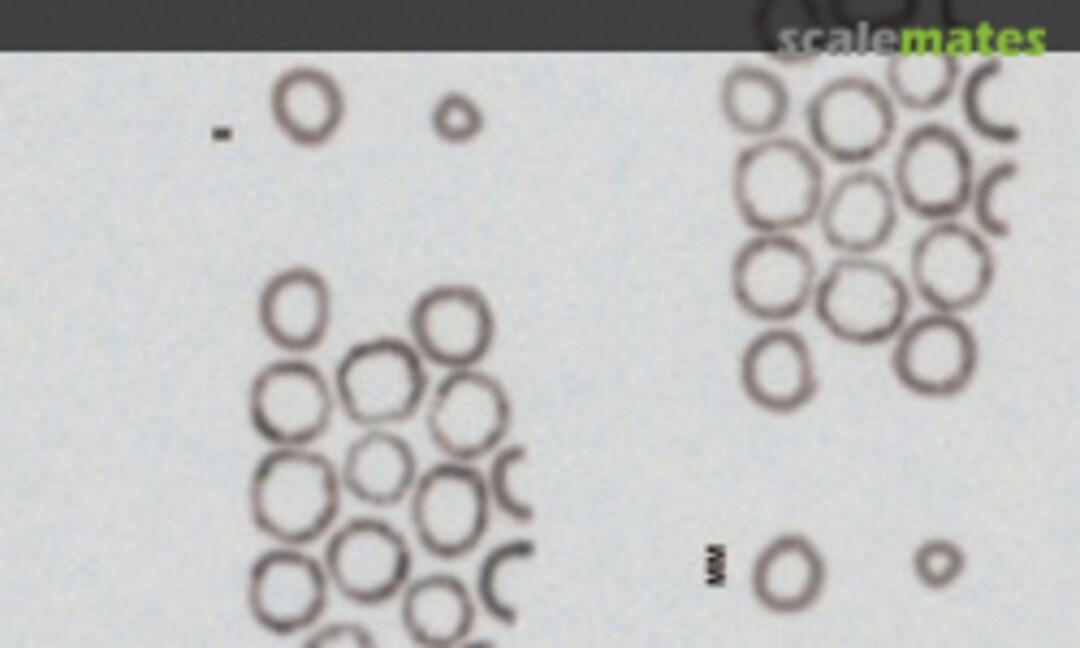

Bf 109 F-2
JG 3, JG 51, JG 54
Eagle Editions | No. EagleCals EC32-136 | 1:32

Box contents
- 1x Decalsheet (waterslide) (multi-colored) View
- 1x Decalsheet (waterslide) (multi-colored) View
- 1x Decalsheet (waterslide) (multi-colored) View
Markings
Messerschmitt Bf 109
Messerschmitt Bf 109 F-2
 Wehrmacht Luftwaffe (German Air Force 1935-1945)
Wehrmacht Luftwaffe (German Air Force 1935-1945)
- 12./JG 51 5
1941 - 2./JG 54 Grünherz << (WNr.6773) (Hptm. Dietrich Hrabak)
July 1941
- 9./JG 54 Grünherz 7 (Uffz. Alfred Döllefeld)
- Stab 1./JG 3 < (WNr.5448) (Hptm. Hans von Hahn)
July 1941